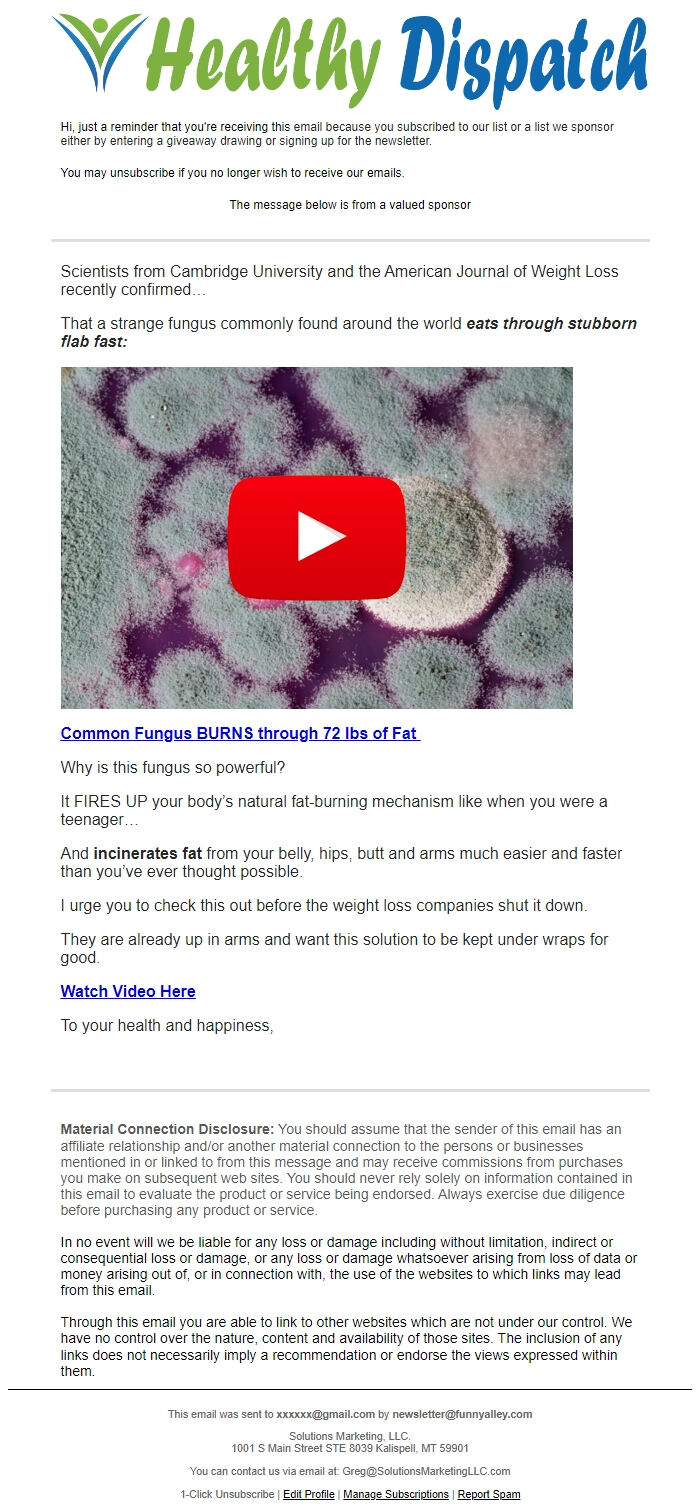
Screenshot of the email generated on import

Email
Ancient Fungus melts through 72 lbs of Fat
| From | Health Dispatch <[email protected]> |
| Subject | Ancient Fungus melts through 72 lbs of Fat |
| Date | June 6, 2024 10:18 PM |
Links have been removed from this email. Learn more in the FAQ.
Links have been removed from this email. Learn more in the FAQ.
This email was sent to [email protected] by [email protected]
Manage Subscriptions
[link removed]
1001 S Main Street STE 8039 Kalispell, MT 59901
Manage Subscriptions
[link removed]
1001 S Main Street STE 8039 Kalispell, MT 59901
Message Analysis
- Sender: n/a
- Political Party: n/a
- Country: n/a
- State/Locality: n/a
- Office: n/a
